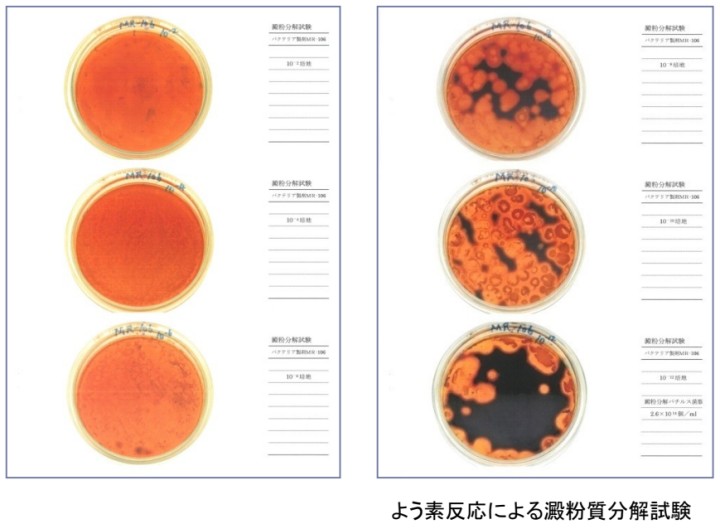

グリーストラップ グリース阻集器 入れるだけ 消臭剤 悪臭 防止 油脂 分解
グリストPon

不衛生で煩雑なグリストラップ清掃を軽減
・週に1回投入するだけ
グリストポンは6種類のバクテリアを配合したバイオタブレットです。グリーストラップ及び雑排水の油脂や汚泥及び硫化水素などの悪臭を軽減します。配合されているバクテリアは通性嫌気性菌のため、エアレーション設備がなくても使用可能です。またグリーストラップ内だけではなく、嫌気性条件下の排水管内でも効果を発揮します。週に1回投入するだけですので、手間がかかりません。
グリストポンは6種類のバクテリアを配合したバイオタブレットです。グリーストラップ及び雑排水の油脂や汚泥及び硫化水素などの悪臭を軽減します。配合されているバクテリアは通性嫌気性菌のため、エアレーション設備がなくても使用可能です。またグリーストラップ内だけではなく、嫌気性条件下の排水管内でも効果を発揮します。週に1回投入するだけですので、手間がかかりません。
グリストPONの特徴
・劇物を使用せず、人と環境にやさしい
・グリーストラップ(グリストラップ、グリス阻集器)にポンといれるだけで投入が簡単
・消臭効果が長続きし、清掃の手間も軽減
➀グリーストラップ(グリストラップ、グリス阻集器)や雑排水層の汚れや悪臭の元を水と二酸化炭素に分解する。
➁硫化➀水素の発生・拡散を軽減し、各設備の劣化を抑え長寿命化を実現することでコスト削減が可能。
➂エアレーションを必要としない通性嫌気性バクテリアであり、空気の届かない配管内でも増殖するので、管内のスカムの堆積も抑制し配管詰りを抑制する。
➃遺伝子解析の結果、バクテリアは人体や動物に害がないセイフティーレベル1であることが第三者専門機関で確認済み。
・グリーストラップ(グリストラップ、グリス阻集器)にポンといれるだけで投入が簡単
・消臭効果が長続きし、清掃の手間も軽減
➀グリーストラップ(グリストラップ、グリス阻集器)や雑排水層の汚れや悪臭の元を水と二酸化炭素に分解する。
➁硫化➀水素の発生・拡散を軽減し、各設備の劣化を抑え長寿命化を実現することでコスト削減が可能。
➂エアレーションを必要としない通性嫌気性バクテリアであり、空気の届かない配管内でも増殖するので、管内のスカムの堆積も抑制し配管詰りを抑制する。
➃遺伝子解析の結果、バクテリアは人体や動物に害がないセイフティーレベル1であることが第三者専門機関で確認済み。
こんな現場でお使いください
・嫌なニオイで困っている
・清掃作業を楽にしたい
・排水管が詰まりやすい
➀グリーストラップ(グリストラップ、グリス阻集器)や雑排水層の汚れや悪臭の元を水と二酸化炭素に分解する。
➁硫化➀水素の発生・拡散を軽減し、各設備の劣化を抑え長寿命化を実現することでコスト削減が可能。
➂エアレーションを必要としない通性嫌気性バクテリアであり、空気の届かない配管内でも増殖するので、管内のスカムの堆積も抑制し配管詰りを抑制する。
➃遺伝子解析の結果、バクテリアは人体や動物に害がないセイフティーレベル1であることが第三者専門機関で確認済み。
・清掃作業を楽にしたい
・排水管が詰まりやすい
➀グリーストラップ(グリストラップ、グリス阻集器)や雑排水層の汚れや悪臭の元を水と二酸化炭素に分解する。
➁硫化➀水素の発生・拡散を軽減し、各設備の劣化を抑え長寿命化を実現することでコスト削減が可能。
➂エアレーションを必要としない通性嫌気性バクテリアであり、空気の届かない配管内でも増殖するので、管内のスカムの堆積も抑制し配管詰りを抑制する。
➃遺伝子解析の結果、バクテリアは人体や動物に害がないセイフティーレベル1であることが第三者専門機関で確認済み。
グリストPONの構成材料
・バクテリア(MR106)
バクテリアのセイフティーレベル1を確認済み。(試験機関:(株)テクノスルガラボ)
・吸水性ポリマーが水分を吸収し、そこに含まれる栄養源でバクテリアを増殖させ、徐溶性のため、効果が持続する。
⇒錠剤タイプの飲み薬にも使用されているもの
・生分解性浮上剤
生分解性のある浮上剤がバクテリアを担持、トラップ内の浮上油中に効率良くバクテリアを分散させる。
バクテリアのセイフティーレベル1を確認済み。(試験機関:(株)テクノスルガラボ)
・吸水性ポリマーが水分を吸収し、そこに含まれる栄養源でバクテリアを増殖させ、徐溶性のため、効果が持続する。
⇒錠剤タイプの飲み薬にも使用されているもの
・生分解性浮上剤
生分解性のある浮上剤がバクテリアを担持、トラップ内の浮上油中に効率良くバクテリアを分散させる。
グリストPONの消臭効果
場所 A施設グリーストラップ(グリストラップ、グリス阻集器)
グリーストラップの容量 50L
投入量 週に1回1個(50g)投与
硫化水素濃度
投入前 2.0ppm
投入(14日後) 0.5ppm
投入(30日後) >0.1ppm
グリーストラップの容量 50L
投入量 週に1回1個(50g)投与
硫化水素濃度
投入前 2.0ppm
投入(14日後) 0.5ppm
投入(30日後) >0.1ppm

グリストPONの使用事例
場所 B社社員食堂
グリーストラップの容量 100L
投入量 週に1個(50g)
導入前 臭いの発生と油脂の固形化している状態。
導入後 2週間で油脂が液状化し、堆積量も約半分以下に軽減した。ニオイも全く感じられない。
グリーストラップの容量 100L
投入量 週に1個(50g)
導入前 臭いの発生と油脂の固形化している状態。
導入後 2週間で油脂が液状化し、堆積量も約半分以下に軽減した。ニオイも全く感じられない。

バイオ最先端技術国で開発された最先端のバクテリア
商品に使用されているバクテリアMR-106は、バイオ最先端技術国アメリカで研究開発されたバチルス菌(納豆菌)を中心とした数種類の善玉バクテリアです。これらのバクテリアは世界最大のバイオバンクATCCに登録済みであり、日本国内の第三者専門機関においてもその効果、安全性が確認されたハイレベルのバクテリアです。
有機物分解能力(澱粉質分解試験)
【澱粉質分解試験】
MR106の澱粉に対する分解能力試験の結果、一般的なバクテリアと比べ澱粉質の分解能力が極めて高いことが確認され、『レベル5』という最高評価を受けました。(試験機関:バチルワールド)従来、うどん店やパン屋などの施設では、澱粉質の含有量が多い排水の処理に苦慮していましたが、MR106を使用する事で澱粉質の分解を速め、排水処理設備の負担を減らすことが可能です。
MR106の澱粉に対する分解能力試験の結果、一般的なバクテリアと比べ澱粉質の分解能力が極めて高いことが確認され、『レベル5』という最高評価を受けました。(試験機関:バチルワールド)従来、うどん店やパン屋などの施設では、澱粉質の含有量が多い排水の処理に苦慮していましたが、MR106を使用する事で澱粉質の分解を速め、排水処理設備の負担を減らすことが可能です。
有機物分解能力(たんぱく質分解試験)
【たんぱく質分解能力試験(クックドミート試験)】
蛋白質(タンパク質)は通常の洗剤(界面活性剤)等では分解されにくい物質のひとつです。MR106の蛋白質に対する分解能力試験の結果、4日間で100%分解する事ができました。この結果から、一般的なバクテリア(通常6~7日間で分解)と比べても、MR106は蛋白質分解能力が高く、分解速度が速いことが証明されました。(試験機関:バチルワールド)蛋白質は有機廃棄物に含まれる代表的な物質であり、特に精肉工場や鮮魚店など蛋白質が多く含まれる排水の処理にはMR106が効果的です。
蛋白質(タンパク質)は通常の洗剤(界面活性剤)等では分解されにくい物質のひとつです。MR106の蛋白質に対する分解能力試験の結果、4日間で100%分解する事ができました。この結果から、一般的なバクテリア(通常6~7日間で分解)と比べても、MR106は蛋白質分解能力が高く、分解速度が速いことが証明されました。(試験機関:バチルワールド)蛋白質は有機廃棄物に含まれる代表的な物質であり、特に精肉工場や鮮魚店など蛋白質が多く含まれる排水の処理にはMR106が効果的です。

抗菌力試験
大腸菌に対する発育抑制試験
雑菌の代表菌である大腸菌(Escherichia coli NBRC 3972)に対する抗菌試験の結果、高い抗菌能力が確認さ
れました。(試験機関:衛生微生物研究センター)
雑菌の抑制効果により、腐敗臭の発生を防止する効果が期待できます。
雑菌の代表菌である大腸菌(Escherichia coli NBRC 3972)に対する抗菌試験の結果、高い抗菌能力が確認さ
れました。(試験機関:衛生微生物研究センター)
雑菌の抑制効果により、腐敗臭の発生を防止する効果が期待できます。

グリストPONの安全性について
【遺伝子解析によるセイフティーレベルの確認試験】
遺伝子解析(16S rDNA-500)の結果、MR106のバクテリアは人体や動物に害がないセイフティーレベル1であること
が確認されました。(試験機関:株式会社テクノスルガラボ)
バイオセイフティーレベルについて(日本細菌学会バイオセイフティー指針より)
セイフティーレベル1:人に疾病を起こし、或いは動物に獣医学的に重要な疾患を起こす可能性のないもの(日和見感染を含む)
遺伝子解析(16S rDNA-500)の結果、MR106のバクテリアは人体や動物に害がないセイフティーレベル1であること
が確認されました。(試験機関:株式会社テクノスルガラボ)
バイオセイフティーレベルについて(日本細菌学会バイオセイフティー指針より)
セイフティーレベル1:人に疾病を起こし、或いは動物に獣医学的に重要な疾患を起こす可能性のないもの(日和見感染を含む)

グリストPONの使用方法
-
1グリーストラップの油脂や生ごみを取り除きます。
-
2グリストポンをグリーストラップ(グリストラップ、グリス阻集器)の1層目にそのまま投入します。その後は週に1回継続します。
※ 使用量の目安 グリーストラップ(グリストラップ、グリス阻集器)の容量100Lに対して1~2個
【応用編 床側溝への取り付け】
グリーストラップ(グリストラップ、グリス阻集器)の上流部にある床側溝へグリストポンを設置することも可能です。排水が流れるたびに徐々に有効成分が溶け出し、グリーストラップに流れ込むためより効果的に使用することができます。
設置方法:ネット※に入れ側溝の蓋の裏などに結束バンド等で固定します。その後は1週間に一度交換します。
※ホームセンター等で販売されている園芸用(野菜収穫用)ネットをお使いください。
成分 バクテリア 吸水性ポリマー 生分解性浮上剤 他
用途 グリーストラップ(グリストラップ、グリス阻集器)及び雑排水槽の消臭及び油脂軽減
グリーストラップ(グリストラップ、グリス阻集器)の上流部にある床側溝へグリストポンを設置することも可能です。排水が流れるたびに徐々に有効成分が溶け出し、グリーストラップに流れ込むためより効果的に使用することができます。
設置方法:ネット※に入れ側溝の蓋の裏などに結束バンド等で固定します。その後は1週間に一度交換します。
※ホームセンター等で販売されている園芸用(野菜収穫用)ネットをお使いください。
成分 バクテリア 吸水性ポリマー 生分解性浮上剤 他
用途 グリーストラップ(グリストラップ、グリス阻集器)及び雑排水槽の消臭及び油脂軽減
グリストPONのご購入はこちら

